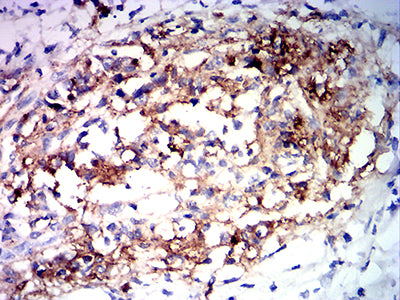

-
分类: 科研抗体货号: 31881别名: HDMX; LSKB; hdm2; ACTFS应用: FCM反应种属: Human
-
分类: 科研抗体货号: 31896别名: CT22; SPA17; SP17-1应用: IHC,FCM反应种属: Human
-
分类: 科研抗体货号: 31894别名: PI; DFN7; GST3; GSTP; FAEES3; HEL-S-22应用: WB,IHC,IF,FCM反应种属: Human
-
分类: 科研抗体货号: 31893别名: CD56; NCAM; MSK39应用: WB,IHC,FCM反应种属: Human, Mouse, Monkey
-
分类: 科研抗体货号: 31910别名: SGB; DGSX; MXR7; SDYS; SGBS; OCI-5; SGBS1; GTR2-2应用: WB,IHC,FCM反应种属: Human
-
分类: 科研抗体货号: 31892别名: CD56; NCAM; MSK39应用: WB,FCM反应种属: Human
-
分类: 科研抗体货号: 31909别名: NFH; CMT2CC应用: IHC,FCM反应种属: Human
-
分类: 科研抗体货号: 31891别名: FSGS7; PAPRS应用: FCM反应种属: Human
-
分类: 科研抗体货号: 31908别名: NFH; CMT2CC应用: IHC反应种属: Human
-
分类: 科研抗体货号: 31890别名: MLP; SMUC; MUC-2应用: IHC,FCM反应种属: Human,Mouse,Rat,Rabbit

鄂公网安备42018502007531号
鄂公网安备42018502007531号

